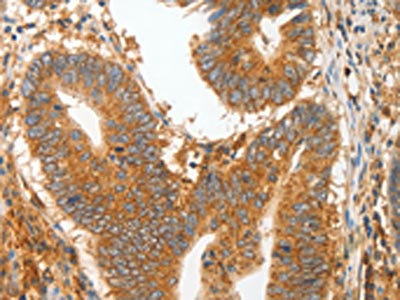

MMP28 Antibody
-
中文名稱:MMP28兔多克隆抗體
-
貨號:CSB-PA789328
-
規格:¥1100
-
圖片:
-
The image on the left is immunohistochemistry of paraffin-embedded Human colon cancer tissue using CSB-PA789328(MMP28 Antibody) at dilution 1/20, on the right is treated with fusion protein. (Original magnification: ×200)
-
Gel: 10%SDS-PAGE, Lysate: 50 μg, Lane: Mouse heart tissue, Primary antibody: CSB-PA789328(MMP28 Antibody) at dilution 1/400, Secondary antibody: Goat anti rabbit IgG at 1/8000 dilution, Exposure time: 5 minutes
-
-
其他:
產品詳情
-
Uniprot No.:
-
基因名:MMP28
-
別名:Epilysin antibody; Matrix metalloproteinase 28 antibody; Matrix metalloproteinase-28 antibody; MM 28 antibody; MM28 antibody; MMP 25 antibody; MMP 28 antibody; MMP-28 antibody; MMP25 antibody; MMP28 antibody; MMP28_HUMAN antibody
-
宿主:Rabbit
-
反應種屬:Human,Mouse
-
免疫原:Fusion protein of Human MMP28
-
免疫原種屬:Homo sapiens (Human)
-
標記方式:Non-conjugated
-
抗體亞型:IgG
-
純化方式:Antigen affinity purification
-
濃度:It differs from different batches. Please contact us to confirm it.
-
保存緩沖液:-20°C, pH7.4 PBS, 0.05% NaN3, 40% Glycerol
-
產品提供形式:Liquid
-
應用范圍:ELISA,WB,IHC
-
推薦稀釋比:
Application Recommended Dilution ELISA 1:1000-1:2000 WB 1:200-1:1000 IHC 1:25-1:100 -
Protocols:
-
儲存條件:Upon receipt, store at -20°C or -80°C. Avoid repeated freeze.
-
貨期:Basically, we can dispatch the products out in 1-3 working days after receiving your orders. Delivery time maybe differs from different purchasing way or location, please kindly consult your local distributors for specific delivery time.
-
用途:For Research Use Only. Not for use in diagnostic or therapeutic procedures.
相關產品
靶點詳情
-
功能:Can degrade casein. Could play a role in tissues homeostasis and repair.
-
基因功能參考文獻:
- Circulating MMP-28 was elevated in atrial fibrillation PMID: 29729262
- Results suggest a crucial role of MMP9 at the early stage of carcinogenesis in the large intestine. The increase in MMP9 and TIMP1 mRNA concentration and the decrease in MMP28 in the large intestinal tissue may be a confirmation of cancer. PMID: 28293015
- These results proved for the first time that epilysin expression was significantly elevated in glioblastoma PMID: 25429835
- A decreased level of IL-33 and an elevated concentration of MMP-28 were found in coronary heart disease patients and correlated with disease severity. PMID: 24710352
- MMP28 mRNA expression is highest in healthy tissues when compared to diseased periodontal tissues. PMID: 24167355
- Data established a seven-gene (AR, ESR2, GATA3, GBX2, KRT16, MMP28 and WNT11) prognostic signature to define a subset of triple-negative breast cancer (TNBC). PMID: 23549873
- Over-expression of MMP28 provides protection against apoptosis induced by either serum-deprivation or treatment with a protein kinase inhibitor. PMID: 22040290
- Gene expression of MMP28 in the intervertebral disk is not regulated by inflammatory mechanisms, is donor-dependent and cannot be positively or negatively linked to the grade of degeneration and only weakly to the occurrence of trauma. PMID: 21801383
- basal expression of MMP-2, MMP-9, MMP-28, and Filaggrin was evaluated in oral keratinocytes to collect information about ability of cigarette smoke to modify basal expression pattern of these key enzymes in the absence of clinical signs in oral epithelium PMID: 21723775
- MMP28 is frequently overexpressed during progression of gastric carcinoma, and contributes to tumor cell invasion and metastasis. PMID: 21615884
- Findings presented here show the first documentation of intervertebral disc expression and production of MMP28 PMID: 20003223
- MMP28 gene expression is regulated by Sp1 transcription factor acetylation. PMID: 20144149
- Expression of MMP-21 and MMP-28 seems to associate with the Merkel cell carcinoma of lesser malignant potential. PMID: 19921252
- Epilysin (MMP-28) expression is associated with cell proliferation during epithelial repair. PMID: 12164918
- Results suggest inhibition of MMP-28 may be beneficial under conditions of dysmyelination. PMID: 18778487
- Data demonstrate that expression of MMP28 alters keratinocyte phenotype towards a more adhesive, less migratory behaviour. PMID: 19375502
- Epilysin (MMP-28) is deposited to the basolateral extracellular matrix of epithelial cells. PMID: 19379669
顯示更多
收起更多
-
亞細胞定位:Secreted, extracellular space, extracellular matrix.
-
蛋白家族:Peptidase M10A family
-
組織特異性:Expressed at high levels in testes and lung. Low levels are detected in kidney, pancreas and skin. Also expressed in fetal lung, brain, skeletal muscle and kidney. Expressed selectively in keratinocytes. Widely expressed in several carcinomas as well. Is
-
數據庫鏈接:
Most popular with customers
-
-
YWHAB Recombinant Monoclonal Antibody
Applications: ELISA, WB, IHC, IF, FC
Species Reactivity: Human, Mouse, Rat
-
Phospho-YAP1 (S127) Recombinant Monoclonal Antibody
Applications: ELISA, WB, IHC
Species Reactivity: Human
-
-
-
-
-